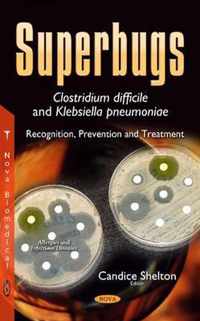
Superbugs -- Clostridium difficile & Klebsiella pneumoniae

kp king online kopen
Ben je op zoek naar kp king? Bekijk onze boeken selectie en zie direct bij welke webshop je kp king online kan kopen. Ga je voor een ebook of paperback van kp king. Zoek ook naar accesoires voor kp king. Zo ben je er helemaal klaar voor. Ontdek ook andere producten en koop vandaag nog je kp king met korting of in de aanbieding. Alles voor veel leesplezier!
Calligraphy paper practice
Vergelijkbare producten zoals Calligraphy paper practice
From Blood Diamonds to the Kimberley Process
in negotiations under the so-called Kimberley Process (KP). A voluntary global agreement came into effect leading to a substantial decline in illicit;
Vergelijkbare producten zoals From Blood Diamonds to the Kimberley Process
Solitons in Two-Dimensional Shallow Water
is to explain some details of the classification problem of the soliton solutions of the KP equation (or KP solitons) and their applications to;
Vergelijkbare producten zoals Solitons in Two-Dimensional Shallow Water
Knokploeg rotterdam zuid 1944-1945
hield de KP-Zuid zich bezig met de voor de KP-ers moeilijkste taak het liquideren van verraders, handlangers van de vijand en criminelen;
Vergelijkbare producten zoals Knokploeg rotterdam zuid 1944-1945
Early Jurassic pterosaur Dorygnathus banthensis (Theodori, 1830) and The Early Jurassic pterosaur Campylognathoides Strand, 1928
Provides a review of the history of the understanding of Dorygnathus, a description of the known spe;...
Vergelijkbare producten zoals Early Jurassic pterosaur Dorygnathus banthensis (Theodori, 1830) and The Early Jurassic pterosaur Campylognathoides Strand, 1928
Konfrontative Padagogik mit Madchen / jungen Frauen
, Sprache: Deutsch, Abstract: Die Konfrontative Padagogik" (KP) lasst sich gleichzeitig als ein (sozial)padagogischer Handlungsstil und eine;
Vergelijkbare producten zoals Konfrontative Padagogik mit Madchen / jungen Frauen
Adults as Learners
A superb, substantive book and one that should cause us to think about the learning society and how ;...
Vergelijkbare producten zoals Adults as Learners
Piet Oberman. De man en de mythe
KP-leider Piet Oberman werd direct onder de rook van Dokkum geboren en bracht er het grootste deel van zijn leven door. Hij maakte deel;
Vergelijkbare producten zoals Piet Oberman. De man en de mythe
Religion, Economics, and Politics in FATA-KP
Districts) are a critical geostrategic area for Pakistan. This work highlights key economic, political, and religious issues in the FATA-KP region;
Vergelijkbare producten zoals Religion, Economics, and Politics in FATA-KP
Superbugs -- Clostridium difficile & Klebsiella pneumoniae
book provides research on Klebsiella pneumoniae infections. Klebsiella pneumoniae producing KPC-type carbapenemase (KPC-Kp) is an emerging;
Vergelijkbare producten zoals Superbugs -- Clostridium difficile & Klebsiella pneumoniae
Managing for Accountability
Managing for Accountability is an invaluable guide for organizations struggling with issues of accou;...
Vergelijkbare producten zoals Managing for Accountability
A Walk - Sanpo
interested in more information, feel free to check KP's official site which can be found on the last page of this book. Konichiwa;
Vergelijkbare producten zoals A Walk - Sanpo
Connected for Health
Permanente members. Called KP HealthConnect, its impact on patient care outcomes, efficiency, safety, and patient engagement and satisfaction already;
Vergelijkbare producten zoals Connected for Health
Connected for Health
Permanente members. Called KP HealthConnect, its impact on patient care outcomes, efficiency, safety, and patient engagement and satisfaction already;
Vergelijkbare producten zoals Connected for Health
Synthesis of Solid Catalysts
This practical book combines recent progress with a discussion of the general aspects of catalyst pr;...
Vergelijkbare producten zoals Synthesis of Solid Catalysts
Glimpses of Soliton Theory
, wedge products and decomposability, the KP Equation and Sato's theory relating the Bilinear KP Equation to the geometry of Grassmannians;
Vergelijkbare producten zoals Glimpses of Soliton Theory
De Knokploeg
Gerrit Gunnink is de zoon van Jan Gunnink, in de oorlog Oom Hein, de leider van de Meppeler KP, de knokploeg. Ook beide andere zonen Klaas;
Vergelijkbare producten zoals De Knokploeg
Reliable Distributed Computing with the Isis Toolkit
Reliable Distributed Computing with the Isis Toolkit presents technical results documenting various ;...
Vergelijkbare producten zoals Reliable Distributed Computing with the Isis Toolkit
Cambridge Tracts in Mathematics
, differential equations arising from classical mechanics, such as the KdV equation and the KP equations, are used here by the authors to introduce the;
Vergelijkbare producten zoals Cambridge Tracts in Mathematics
Cambridge Tracts in Mathematics
, differential equations arising from classical mechanics, such as the KdV equation and the KP equations, are used here by the authors to introduce the;
Vergelijkbare producten zoals Cambridge Tracts in Mathematics
Einde inhoud
Geen pagina's meer om te laden'